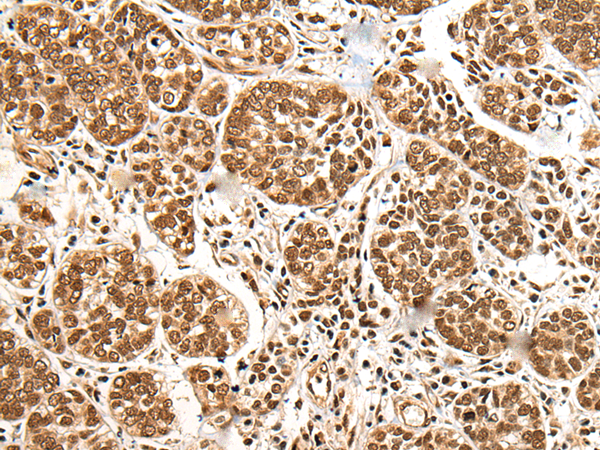

中文名稱:兔抗BRSK1多克隆抗體
|
Background: |
The phosphorylation and dephosphorylation of proteins on serine and threonine residues is an essential means of regulating a broad range of cellular functions in eukaryotes, including cell division, homeostasis and apoptosis. A group of proteins that are intimately involved in this process are the serine/threonine (Ser/Thr) protein kinases. BRSK1 (BR serine/threonine-protein kinase 1), also known as SAD1, is a 794 amino acid protein that localizes to both the nucleus and the cytoplasm and contains one UBA domain and one protein kinase domain. Expressed in a variety of tissues with highest expression in testis and brain, BRSK1 uses magensium as a cofactor to catalyze the ATP-dependent phosphorylation of target proteins, including Wee 1 and Cdc25B. Via its kinase activity toward proteins that are involved in microtubule assembly, BRSK1 plays an essential role in neuronal polarization and may be involved in regulating cell cycle arrest in response to DNA damage, Two isoforms of BRSK1 exist due to alternative splicing events. |
|
Applications: |
ELISA, IHC |
|
Name of antibody: |
BRSK1 |
|
Immunogen: |
Fusion protein of human BRSK1 |
|
Full name: |
BR serine/threonine kinase 1 |
|
Synonyms: |
hSAD1 |
|
SwissProt: |
Q8TDC3 |
|
ELISA Recommended dilution: |
5000-10000 |
|
IHC positive control: |
Human esophagus cancer and human ovarian cancer |
|
IHC Recommend dilution: |
50-300 |
購物車
幫助
021-54845833/15800441009
